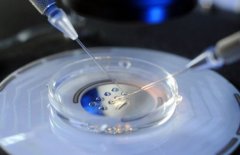
什么是打降调针?降调期间要考虑什么问题?

试管科普

-
 输精管堵塞怎么办?输精管堵塞能试管吗?
输精管堵塞怎么办?输精管堵塞能试管吗?输精管阻塞是一种常见的男性不育症,它会导致精子无法顺利进入射精液中,从而影响受孕。那么如果患有输精管阻塞,能否通过试管技术实现生育呢? 我们需要了解一下试管技术。简
作者:兰兰 52 发布时间:2026-05-11 -
 输卵管黏连怎么办?输卵管黏连做试管的方法是什么?
输卵管黏连怎么办?输卵管黏连做试管的方法是什么?输卵管黏连是一种常见的不孕症原因。在正常情况下,女性的卵子从卵巢中释放出来,在输卵管中与精子结合受精,然后移动到宫腔中着床发育成胎儿。但当输卵管被黏连时,这个过程就会受
作者:兰兰 59 发布时间:2026-05-11 -
 什么是降调?降调后多久取卵最合适?
什么是降调?降调后多久取卵最合适?人工受孕技术是一项非常高级的医疗技术,其中的“试管”技术已经被广泛应用于生育诊断和治疗中。然而,对于想通过人工受孕实现生育愿望的夫妇来说,了解如何选择正确的取卵时间
作者:兰兰 52 发布时间:2026-05-11 -
 附睾炎是什么病?如何治疗附睾炎?
附睾炎是什么病?如何治疗附睾炎?试管是一种辅助生殖技术,可以帮助不孕不育夫妻实现生育梦想。但是对于男性患有附睾炎的情况下,是否可以进行试管呢?本文将为您一一解答。 附睾炎是指男性生殖系统中的附睾发
作者:兰兰 104 发布时间:2026-05-11 -
 长效降调针不适合哪些人?长效降调针能管多久?
长效降调针不适合哪些人?长效降调针能管多久?长效降调针是一种常用的治疗高血压、心绞痛、心力衰竭等心脑血管疾病的药物。但是它并不适合所有人使用。那么长效降调针到底适合谁?有哪些禁忌症呢? 长效降调针适用于血压持续升高的
作者:兰兰 130 发布时间:2026-05-11 -
 锻炼身体的好处有哪些?健身对试管成功率有什么作用?
锻炼身体的好处有哪些?健身对试管成功率有什么作用?试管是一种辅助生殖技术,许多夫妻通过这种方式实现了生育梦想。然而,试管并非百分之百成功,失败的原因很多,其中一项重要因素就是夫妻双方的身体状况。最近的研究发现,
作者:兰兰 110 发布时间:2026-05-11 -
 苏州试管进周前必做准备清单,一个都不能少!
苏州试管进周前必做准备清单,一个都不能少!在启程前往苏州进行试管周期之前,首要任务是精心规划行程与住宿细节,确保能准时抵达医院,无缝衔接治疗流程。紧接着,需全面完成所有必要的体检与化验项目,涵盖血常规、生殖
作者:雨诗 110 发布时间:2026-05-11 -
 试管适合哪些人群?试管成功率怎么样?
试管适合哪些人群?试管成功率怎么样?试管是一项现代医学技术,可以帮助无法怀孕的夫妻实现生育梦想。但并不是所有人都适合做试管。接下来我们将为您介绍那些适合做试管的人群。 试管适合哪些人群 女性年
作者:兰兰 179 发布时间:2026-05-11 -
什么是打降调针?降调期间要考虑什么问题?
什么是打降调针?降调期间要考虑什么问题?在人们日常生活中,常常会出现一些季节性的变化,如气温、降雨量、空气质量等。其中最为明显的就是降调期间的到来,这个时候我们需要注意哪些事项呢?下面为大家详细介绍。 降调期间注
作者:兰兰 69 发布时间:2026-05-11 -
 高龄试管与自然受孕哪个好?试管成功率怎么样?
高龄试管与自然受孕哪个好?试管成功率怎么样?随着社会进步,越来越多的女性选择推迟生育。然而,随着年龄的增长,怀孕变得越来越困难。对于高龄女性而言,是选择试管还是自然怀孕更好呢?本文将从多个方面进行探讨。 高龄试管
作者:兰兰 142 发布时间:2026-05-11 -
 检查出染色体异常还能要孩子吗?染色体异常能做试管吗?
检查出染色体异常还能要孩子吗?染色体异常能做试管吗?不少夫妻在备孕过程中发现自身携带染色体异常,这时很多人会选择试管来解决问题。但问题来了,染色体异常做试管可以尝试几次呢?本篇文章将为您详细。 具体相关内容,小编为您
作者:木易 192 发布时间:2026-05-11 -
 干货!试管你想知道的一些事儿
干货!试管你想知道的一些事儿试管是一项昂贵的治疗方法,许多人会担心如果流产了是否需要再次支付费用。事实上这取决于你所签署的合同和医院的政策。 试管流产后是否需要再次支付费用? 如果你在进行试管
作者:木易 166 发布时间:2026-05-11
